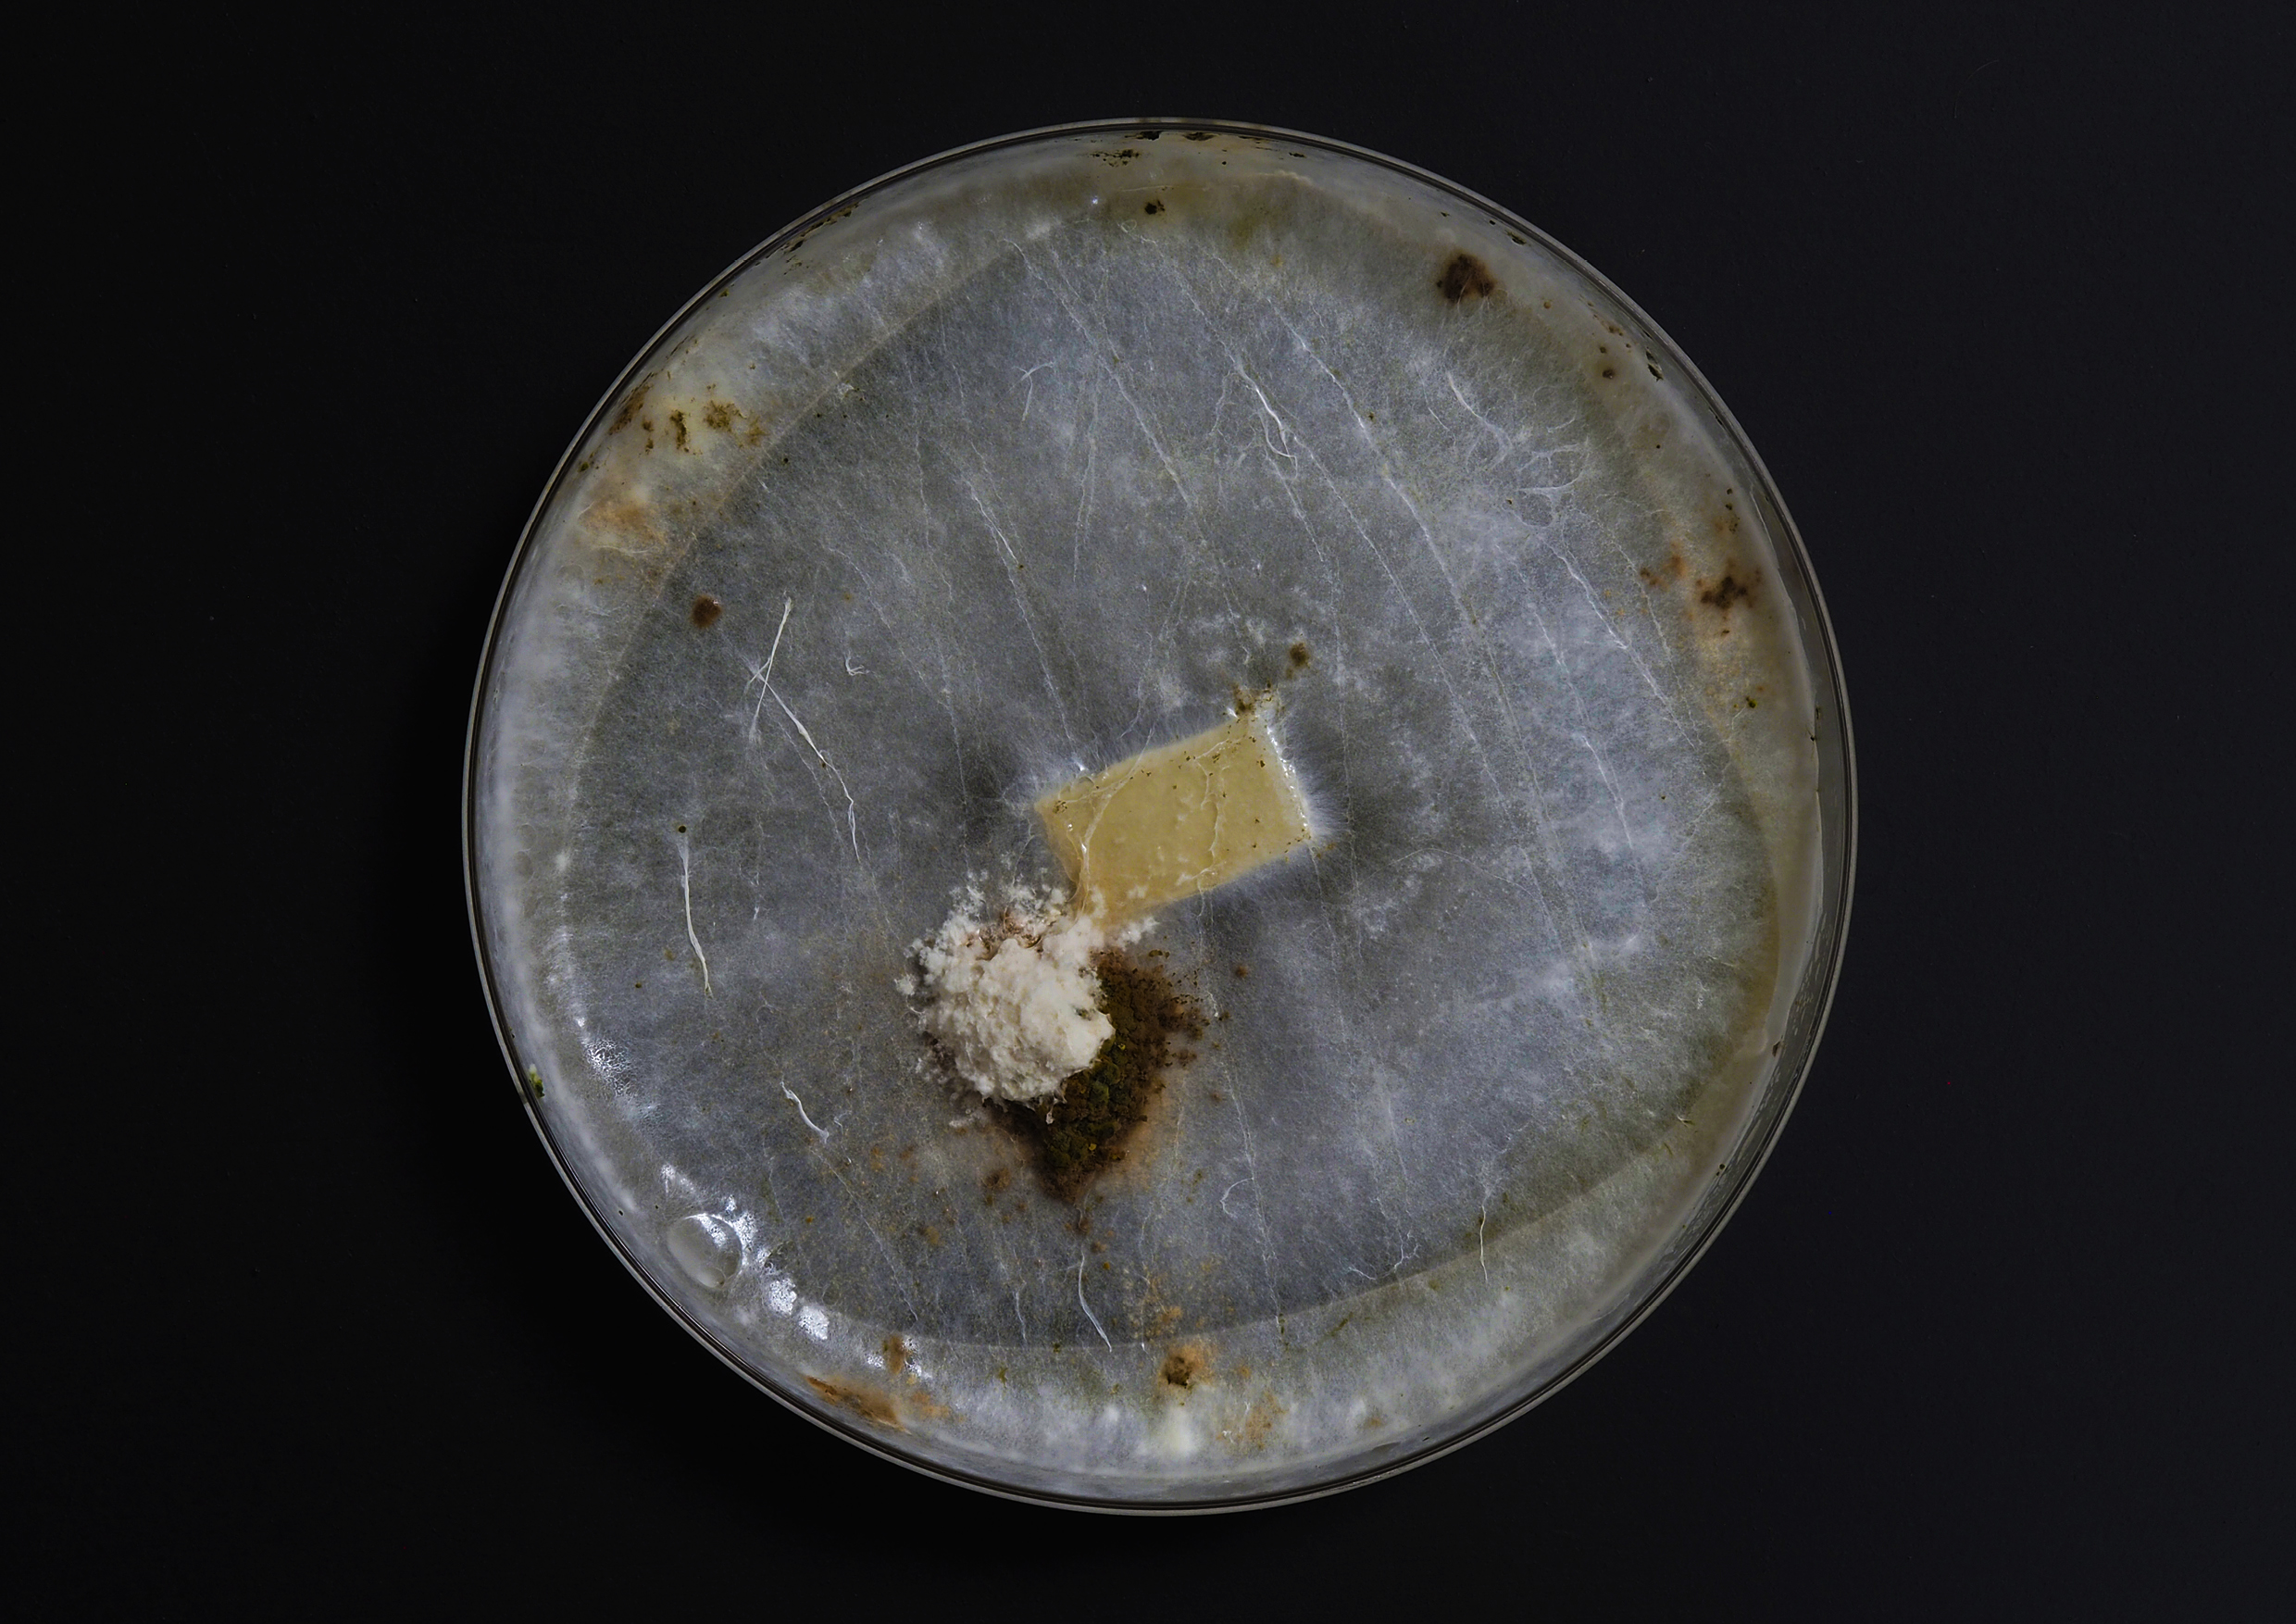

On Lichen
Relational Selves and the Politics of Symbiosis
Lichens challenge the notion of individuality by existing as symbiotic collectives between a fungus and a phototroph, typically an alga and/or cyanobacterium, unsettling inherited distinctions between self and other. Operating as agents of deep time, they expose taxonomy, hierarchy, and autonomy as contingent constructs shaped by political and colonial frameworks of knowledge production.
This research engages lichen (Cladonia asahinae) not as a biological curiosity but as a conceptual interlocutor. Through several experimental isolations of fungal components in a professional laboratory setting, the work stages a tension between separation and entanglement, echoing broader impulses to control, categorize, and purify. The attempt to extract the fungal component from a relational organism reveals “individuality” as a fiction, one that collapses under ecological and social complexity.
Rather than producing resolution, the project foregrounds uncertainty. It positions symbiosis as a critical lens through which to reconsider agency, governance, and coexistence, insisting that relationality is not an exception but a fundamental condition shaping bodies, materials, and systems of thought.